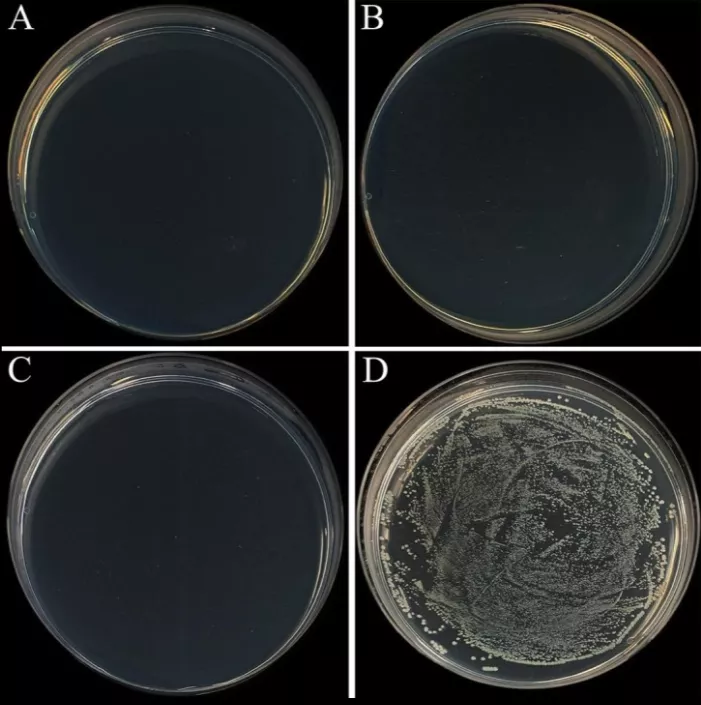

【导读】全球首次!港大研究团队开发出一种能杀灭新冠病毒的含铜不锈钢材料,6小时即可灭活99.99%的新冠病毒,对于H1N1禽流感病毒和大肠杆菌均有显著杀灭作用。
不锈钢,还能灭菌杀毒?
对,不但能,杀的还是新冠病毒!
近日,香港大学工程学院机械工程系黄明欣教授领导的团队,与港大李嘉诚医学院免疫与感染研究中心潘烈文教授的研究团队合作,发明了一种高铜含量的不锈钢,能成功杀灭存留于其表面包括新冠病毒在内的抗病原体。
这是全球已知首个有抗病原体功能的不锈钢。
论文地址:
https://pubmed.ncbi.nlm.nih.gov/34853550/
这一成果于11月25日在《化学工程》学术期刊上(Chemical Engineering Journal)发表,论文题为『可抗击新冠病毒的抗病原体不锈钢』(“Anti-pathogen stainless steel combating COVID-19”)。
本研究论文通讯作者、香港大学机械工程系教授黄明欣
研究人员表示,他们新开发的不锈钢合金可以在3小时内灭活 99.75% 的 SARS-CoV-2 病毒,在6小时内灭活 99.99%。
效果这么好,到底加入了什么神奇的成分?
答案是两种常见的元素:铜和银。
作为最流行的两种无机抗菌元素,银和铜具有业界广为人知的广谱抗菌、抗病毒的能力,而且对动物细胞的毒性很低,是制备抗菌类材料的常用添加物。
之前的研究发现,纯铜对 SARS-CoV-2 和甲型流感病毒 (H1N1) 均表现出优异的抗病毒效率。然而,在公共场所用纯铜代替不锈钢制品,成本高、强度低、耐腐蚀能力差,不切实际。
另一种方法是把铜通过镀层或离子注入的形式加入不锈钢,获得抗菌效果。但使用这种方法,表面涂层的损坏会显著影响不锈钢的抗菌性能,导致使用寿命有限。
材料制备与实验
为了解决这两个局限,研究人员使用铜粉和纳米级氧化银粉末,与不锈钢粉混合,制备不同质量分数的铜-不锈钢与银-不锈钢混合物,再通过烧结形成盘装固体。同时,以纯铜、纯银、纯不锈钢作为实验的对照组。
然后,将含有新冠病毒、大肠杆菌、H1N1病毒等多种病原体的培养液滴在测试材料上,定期观察剩余病毒的浓度。
6小时灭活99.99%新冠病毒
实验观测共进行48小时,结果显示,用铜和银与不锈钢进行不同比例的混合,对上述多种病原体均有很理想的灭活作用。
如上图所示,对于新冠病毒,质量分数为20%的铜-不锈钢混合材料,在实验进行6小时后,可见病毒下降到不足0.01%,实现了对99.99%新冠病毒的灭活。
对于H1N1禽流感病毒,实验中的复合材料的灭活作用同样十分明显,灭活效果更好。
测试材料上的细菌和病毒繁殖情况,左下为纯铜,右下方为未添加铜的不锈钢。
差距一目了然。
而且,这种混合材料的抗菌性能长期有效,即使其在使用过程中材料不断受到破坏,也能长时间保持对多种病原体的杀灭作用。
而且,这种材料可以使用现有的「粉末冶金」技术大量生产,成本效应很高,便于推广使用。
目前,新冠Omicron变体病毒的重新流行,为全球抗击疫情形势又一次敲响了警钟,在此大背景下,港大的这项研究更显出其重要意义。
如果这项创新被证明确实有效,既便宜又可以推广,将显著降低对机场、火车站等公共交通区域以及电影院、体育场等人群聚集地的消毒成本。
目前,研究人员在与业内寻求合作,以进一步测试这种材料在替代不锈钢材料方面的应用,比如电梯按钮、门把手和楼梯扶手等公共区域中人们最常接触的地方。
参考资料:
https://www.chinadailyhk.com/article/250824
https://www.hku.hk/press/news_detail_23696.html
https://pubmed.ncbi.nlm.nih.gov/34853550/
免责声明:本网站所转载的文字、图片与视频资料版权归原创作者所有,如果涉及侵权,请第一时间联系本网删除。
相关文章
官方微信
《中国腐蚀与防护网电子期刊》征订启事
- 投稿联系:编辑部
- 电话:010-62316606-806
- 邮箱:fsfhzy666@163.com
- 中国腐蚀与防护网官方QQ群:140808414
点击排行
PPT新闻
“海洋金属”——钛合金在舰船的
点击数:7265
腐蚀与“海上丝绸之路”
点击数:5842